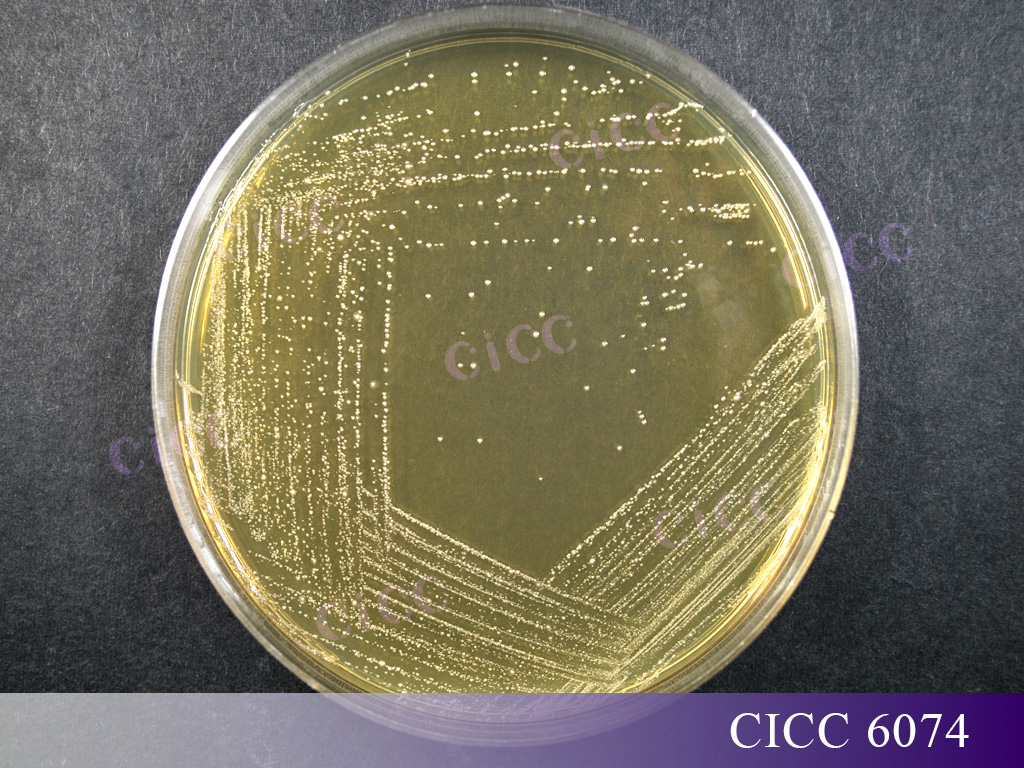
菌落.jpg

嗜酸乳桿菌
嗜酸乳桿菌是人體腸道中的重要微生物,具有諸多益生功效,擁有長期的安全使用歷史[1],已被列入我國《可用于食品的菌種名單》、歐洲食品安全局(European Food Safety Authority,EFSA)安全資格認(rèn)證(Qualified Presumption of Safety,QPS)名單和美國食品藥品監(jiān)督管理局(FDA)公認(rèn)安全物質(zhì)(Generally recognized as safe, GRAS)名單,被廣泛應(yīng)用于用于食品、飼料等領(lǐng)域。
本文將詳細(xì)介紹嗜酸乳桿菌的分類歷史、研究進(jìn)展、應(yīng)用情況、國內(nèi)外保藏情況以及特征特性。
一、分類歷史
1900年:Moro從嬰兒糞便中分離出一株革蘭氏陽性的無芽孢桿菌,并命名為嗜酸芽孢桿菌(Bacillus acidophilus)[2,3]。以現(xiàn)在的分類學(xué)標(biāo)準(zhǔn),Moro當(dāng)時對該菌株的描述并不完整,該名稱不能被視為有效命名。
后有研究者對其進(jìn)一步研究,發(fā)現(xiàn)保藏在Král保藏中心的該菌種與Moro文章中描述的菌株不符,無法確認(rèn)Moro分離出的菌株具體特性[4,5]。
1920年:Holland將該菌從芽孢桿菌屬重命名為乳桿菌屬,但未提供任何描述或引用先前的描述,也未提出過新名稱。因此,該名稱不能被視為有效發(fā)布[6]。
1923年:《伯杰氏手冊》第1版中給出了嗜酸乳桿菌這個名稱,但沒有引用作者信息,不能被視為有效發(fā)表。《伯杰氏手冊》第2版至第7版都引用了Holland作為該名稱的作者,證明該名稱已被廣泛使用,但從未被有效發(fā)表[7]。
1970年:Hansen和Mocqquot詳細(xì)描述了該菌種菌株特性,并在微生物學(xué)年會與分類學(xué)小組委員會(International Conference on Systems Biology)的幫助下指定了模式菌株ATCC 4356[7,8],嗜酸乳桿菌Lactobacillus acidophilus被正式提出并有效公布,并于1980年收錄于《細(xì)菌名稱確認(rèn)名錄》(Approved Lists of Bacterial Names)[9]。
二、研究進(jìn)展
嗜酸乳桿菌是腸道中最重要的益生菌之一,與宿主健康息息相關(guān),在腸道中能夠調(diào)節(jié)菌群、抑制病原菌生長,同時具有改善心血管疾病、抑制腫瘤等作用。
1. 在胃腸道健康方面
嗜酸乳桿菌通過競爭排斥、促進(jìn)腸道中有益微生物的增殖、產(chǎn)活性代謝物產(chǎn)物和增強(qiáng)上皮細(xì)胞屏障等方式,起到調(diào)節(jié)消化系統(tǒng)健康的作用。Kim[10]等人研究表明,嗜酸乳桿菌可以通過調(diào)節(jié)炎癥相關(guān)細(xì)胞因子的分泌、增加腸道菌群多樣性以及提高代謝產(chǎn)物中短鏈脂肪酸的含量的方式起到緩解DSS誘導(dǎo)小鼠結(jié)腸炎的效果。Xiao[11]等人通過臨床試驗(yàn)發(fā)現(xiàn),慢性腹瀉患者在服用熱滅活嗜酸乳桿菌制劑后,排便頻率下降,同時腹痛、腹脹的情況得到緩解。此外,Rana Al-Sadi[12]通過細(xì)胞及動物實(shí)驗(yàn)發(fā)現(xiàn),嗜酸乳桿菌能增強(qiáng)上皮細(xì)胞緊密連接,改善腸道屏障缺陷,進(jìn)而起到預(yù)防炎癥性腸病的效果。
2. 在抑制致病菌方面
嗜酸乳桿菌可以通過產(chǎn)生細(xì)菌素等活性代謝產(chǎn)物、降低pH、競爭粘附位點(diǎn)的方式,起到抑制致病菌的功效。曲曉娟等人研究表明,嗜酸乳桿菌能夠通過抑制白色念珠菌在口腔上皮細(xì)胞中的粘附,進(jìn)而起到降低小鼠口腔白色念珠菌的感染率的作用[13]。孫華迪[14]等人發(fā)現(xiàn),嗜酸乳桿菌通過產(chǎn)細(xì)菌素,對大腸桿菌、金黃色葡萄球菌、沙門桿菌、炭疽桿菌、李斯特氏菌、枯草桿菌以及無乳鏈球菌起到拮抗作用。Sandra[15]通過體外研究發(fā)現(xiàn),嗜酸乳桿菌可以產(chǎn)有機(jī)酸,降低環(huán)境pH,進(jìn)而起到抑制致病菌的作用。
3. 在改善心血管疾病方面
心血管疾病在全球范圍內(nèi)發(fā)病率不斷升高,每年全世界約有1/3的人死于心血管疾病。血液膽固醇升高是導(dǎo)致心血管疾病的重要原因之一,嗜酸乳桿菌可以降低膽固醇,進(jìn)而起到預(yù)防心血管疾病的功效[16]。Park[17]等研究發(fā)現(xiàn),補(bǔ)充嗜酸乳桿菌可以降低高膽固醇血癥大鼠血清中總膽固醇含量,并增加糞便代謝產(chǎn)物中酸性固醇的含量。Song[18]等人發(fā)現(xiàn),灌胃嗜酸乳桿菌可以抑制高脂飲食小鼠體重的增加,并通過增加肝臟中低密度脂蛋白受體的表達(dá)來降低血漿中密度脂蛋白膽固醇的含量。
4. 在抑制腫瘤方面
嗜酸乳桿菌可以通過誘導(dǎo)腫瘤細(xì)胞的凋亡、調(diào)節(jié)免疫應(yīng)答等方式,起到抑制腫瘤的作用。體外實(shí)驗(yàn)研究表明[19],嗜酸乳桿菌的上清液和細(xì)胞提取物能夠抑制人結(jié)腸癌細(xì)胞Caco-2增殖,并促進(jìn)細(xì)胞凋亡,進(jìn)而降低癌細(xì)胞遷移和侵襲的能力。Maroof[20]研究表明,補(bǔ)充嗜酸乳桿菌可以激活乳腺癌模型小鼠自然殺傷細(xì)胞,調(diào)節(jié)IFN-γ等細(xì)胞因子的產(chǎn)生,進(jìn)而起到抑制腫瘤增長的效果。Chen[21]等發(fā)現(xiàn),灌胃嗜酸乳桿菌可以通過下調(diào)結(jié)腸癌小鼠結(jié)腸及脾臟組織中趨化因子受體CXCR4的表達(dá),起到延緩結(jié)腸腫瘤增長并促進(jìn)癌細(xì)胞凋亡的作用。
三、應(yīng)用情況
1. 食品領(lǐng)域
嗜酸乳桿菌在常用于發(fā)酵食品的生產(chǎn),嗜酸乳桿菌與德氏乳桿菌保加利亞亞種及嗜熱鏈球菌復(fù)配制備發(fā)酵乳,可以縮短發(fā)酵時間、增加產(chǎn)品粘稠度,同時提高產(chǎn)品中雙乙酰等典型風(fēng)味物質(zhì)的含量[22];在干酪生產(chǎn)中,添加嗜酸乳桿菌可以增加產(chǎn)品的彈性和凝聚性,提升產(chǎn)品口感[23];此外,嗜酸乳桿菌用于豆乳發(fā)酵,可以明顯減少產(chǎn)品的豆腥味[24]。除發(fā)酵特性外,嗜酸乳桿菌常作為益生菌添加于發(fā)酵乳、奶粉、果汁等食品中,發(fā)揮著抑菌、緩解腹瀉及改善腸道健康等功能[25,26]。
2. 飼料領(lǐng)域
在飼料中添加嗜酸乳桿菌可以起到促進(jìn)生長、預(yù)防疾病、提高飼料利用率的效果。在水產(chǎn)養(yǎng)殖中,嗜酸乳桿菌能夠改善水生動物腸道菌群結(jié)構(gòu),提高養(yǎng)分消化吸收能力,增強(qiáng)免疫功能,改善水質(zhì)狀況[27]。在肉雞養(yǎng)殖中,補(bǔ)充嗜酸乳桿菌可以顯著提高肉雞體重增長的速度,同時降低血清中膽固醇的含量[28]。嗜酸乳桿菌用于育肥豬養(yǎng)殖,可以提高豬酮體產(chǎn)量,增加瘦肉比率,同時提高豬肉的感官品質(zhì)[29]。
四、國內(nèi)外保藏情況
嗜酸乳桿菌在國際各大保藏中心均有保藏,其中CICC保藏有模式菌株CICC 6075,與多家國際知名菌種保藏中心模式菌株等同編號,如:如:ATCC 4356、DSM 20079、JCM 1132,可用于分類學(xué)研究。
此外,CICC還保藏有不同來源及用途的,以及具有應(yīng)用潛力的嗜酸乳桿菌共25株,如:
CICC 22162,CICC 20248、CICC 20250、CICC 20709、CICC 20710等可用于酸奶及乳制品發(fā)酵。
CICC 6074,用于GB 4789.35-2023 《食品安全國家標(biāo)準(zhǔn) 食品微生物學(xué)檢驗(yàn) 乳酸菌檢驗(yàn)》陽性對照菌株。
五、特征特性
1. 革蘭氏陽性菌,菌體呈細(xì)長桿狀(0.6-0.9 μm ×1.5-6.0 μm),兩端為圓形,單個、成對或成鏈排列,不運(yùn)動,無芽孢。


2. 菌落為圓形、白色、凸起,表面光滑、濕潤,邊緣整齊。
3. 最適生長溫度為35~38℃,耐熱性差,最適生長pH值為5.5~6.0,能在其它乳酸菌不能生長的環(huán)境中生長繁殖。
4. 能利用葡萄糖、果糖、乳糖、蔗糖進(jìn)行同型發(fā)酵,產(chǎn)生D-/L-乳酸;蛋白質(zhì)分解能力弱,在乳中的產(chǎn)酸速率偏低。
中國工業(yè)微生物菌種保藏管理中心(CICC)致力于提供高質(zhì)量的微生物資源和專業(yè)化的技術(shù)服務(wù),中心保藏有14,000余株各類工業(yè)微生物菌種資源,其中乳酸菌1500余株,包含眾多性能優(yōu)良的嗜酸乳桿菌,希望通過CICC對菌種的收集、保藏、質(zhì)控和共享,未來使嗜酸乳桿菌得到更多的研究與產(chǎn)業(yè)化應(yīng)用,服務(wù)人民美好生活。
參考文獻(xiàn)
[1] Widyastuti Y, Rohmatussolihat, Febrisiantosa A .The Role of Lactic Acid Bacteria in Milk Fermentation[J].Food and Nutrition Sciences, 2014, 05(4):435-442.
[2] Moro E, Ueber die nach Gram farbbaren Bacillen des S?uglingsstuhles[J], Wiener klin. Wochenschr, 1900(13), 114–115.
[3] Moro E, Ueber den Bacillus acidophilus n. spec. Ein Beitrag zur Kenntniss der normalen Darmbacterien des S?uglings[J],Jahrb. Kinderheilk, 1900(352) , 38–55.
[4] S.A.D.Orla-Jensen u. O. Winther, Bacterium bifidum und Thermobacterium intestinale[J], Zbl. Bakt., II. Abt, 1936(93), 321.
[5] Rogosa M L, Wisenman R F, Mitchell J A, et al. Species differentiation of oral lactobacilli from man including description of Lactobacillus salivarius nov. spec. and lactobacillus Cellobiosus nov. spec[J]. J Bacteriol. 1953 Jun;65(6):681-699.
[6] Holland D F .Generic index of the commoner forms of bacteria[J]. Journal of Bacteriology, 1920, 2(5):505.
[7] Hansen P A , Mocquot G .Lactobacillus acidophilus (Moro) comb. nov.[J].Int.j.syst.bacteriol, 1970, 20(3):325-327.
[8] Hansen P A .Type strains of Lactobacillus species. A report by the Taxonomic Subcommittee on Lactobacilli and Closely Related Organisms. A subcommittee of the International Committee on Nomenclature of Bacteria of the International Association of Microbiological Socie[M]. 1968.
[9] Skerman V B D , Mcgowan V , Sneath P H A .Approved Lists of Bacterial Names[J].Medical Journal of Australia, 1980, 2(1):3-4.
[10] Selle K , Lightfoot Y L , Yang T. SIGNR 3‐dependent immune regulation by Lactobacillus acidophilus surface layer protein A in colitis [J]. The EMBO journal, 2015, 34(7): 881-895.
[11] Xiao S D, Zhang Z D, Lu H, et al. Multicenter, randomized, controlled trial of heat-killed Lactobacillus acidophilus LB in patients with chronic diarrhea [J]. Advances in therapy, 2003, 20: 253-260.
[12] AL-Sadi R, NighoT P, Noghot M, et al. Lactobacillus acidophilus induces a strain-specific and toll-like receptor 2–dependent enhancement of intestinal epithelial tight junction barrier and protection against intestinal inflammation [J]. The American Journal of Pathology, 2021, 191(5): 872-884.
[13] 曲曉娟, 劉鐵玉, 劉為國, et al. 嗜酸乳桿菌對口腔白色念珠菌感染的抑制作用 [J]. 中國公共衛(wèi)生, 2006, (08): 958-859.
[14] 孫華迪, 蔡麗麗, 陳曉靜, et al. 具有廣譜抑菌特性的嗜酸乳桿菌細(xì)菌素活性研究 [J]. 河南工業(yè)大學(xué)學(xué)報(自然科學(xué)版), 2020, 41(04): 84-89.
[15] Tejero-Sari?ena S, Barlow J, Costabile A, et al. In vitro evaluation of the antimicrobial activity of a range of probiotics against pathogens: evidence for the effects of organic acids [J]. Anaerobe, 2012, 18(5): 530-538.
[16] Gao H, Li X, Chen X, et al. The functional roles of Lactobacillus acidophilus in different physiological and pathological processes [J]. Journal of microbiology and biotechnology, 2022, 32(10): 1226.
[17] Park Y H, Kim J G, Shin Y W, et al. Effect of dietary inclusion of Lactobacillus acidophilus ATCC 43121 on cholesterol metabolism in rats [J]. Journal of microbiology and biotechnology, 2007, 17(4): 655-662.
[18] Song M, Park S, Lee H, et al. Effect of Lactobacillus acidophilus NS1 on plasma cholesterol levels in diet-induced obese mice [J]. Journal of Dairy Science, 2015, 98(3): 1492-1501.
[19] Dallal M M S, Mojarrad M, Baghbani F, et al. Effects of probiotic Lactobacillus acidophilus and Lactobacillus casei on colorectal tumor cells activity (CaCo-2) [J]. Archives of Iranian medicine, 2015, 18(3): 167-172.
[20] Maroof H, Hassan Z M, Mobarez A M, et al. Lactobacillus acidophilus could modulate the immune response against breast cancer in murine model [J]. Journal of clinical immunology, 2012, 32: 1353-1359.
[21] Chen C C, Lin W C, Kong M S, et al. Oral inoculation of probiotics Lactobacillus acidophilus NCFM suppresses tumour growth both in segmental orthotopic colon cancer and extra-intestinal tissue [J]. British Journal of Nutrition, 2012, 107(11): 1623-1634.
[22] 李子葉, 李柏良, 關(guān)嘉琪, et al. 嗜酸乳桿菌KLDS 1.0901對酸奶發(fā)酵特性及抗氧化活性的影響 [J]. 食品研究與開發(fā), 2019, 40(22): 49-56.
[23] 林超.嗜酸乳桿菌在益生干酪中的應(yīng)用研究[D].東北農(nóng)業(yè)大學(xué),2013.
[24] Shurtleff W, Aoyagi A. History of Soy Yogurt, Soy Acidophilus Milk and Other Cultured Soymilks (1918-2012) [M]. Soyinfo Center, 2012.
[25] Millette M , Luquet F M , Lacroix M .In vitro growth control of selected pathogens by Lactobacillus acidophilus- and Lactobacillus casei-fermented milk.[J].Letters in Applied Microbiology, 2010, 44(3):314-319.
[26] Sanders M E , Klaenhammer T R .Invited review: the scientific basis of Lactobacillus acidophilus NCFM functionality as a probiotic.[J].Journal of Dairy Science, 2001, 84(2):319-331.
[27] 張露, 周劍, 段元亮, et al. 嗜酸乳桿菌在水產(chǎn)養(yǎng)殖中的應(yīng)用研究進(jìn)展 [J]. 飼料研究, 2024, (17): 155-161.
[28] Vantsawa P, Umar T, Bulus T. Effects of probiotic Lactobacillus acidophilus on performance of broiler chickens [J]. Direct Research Journal of Agriculture and Food Science, 2017, 5(8): 302-306.
[29] Dowarah R, Verma A K, Agarwal N, et al. Efficacy of species-specific probiotic Pediococcus acidilactici FT28 on blood biochemical profile, carcass traits and physicochemical properties of meat in fattening pigs [J]. Research in veterinary science, 2018, 117: 60-64.


